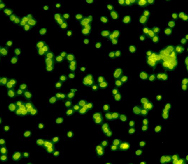

Methanogenium cariaci
| Image |
|---|
|
| Taxonomy |
|---|
| Class: Methanomicrobia |
| Order: Methanomicrobiales |
| Family: Methanomicrobiaceae |
| Genus: Methanogenium |
| Temperature [°C] |
|---|
| Temperature min.: 15 |
| Temperature max.: 35 |
| Temperature optimal min.: 20 |
| Temperature optimal max.: 25 |
| Alcalinity ↷ |
|---|
| pH min.: 6 |
| pH max.: 7.5 |
| pH optimal min.: 6.8 |
| pH optimal max.: 7.2 |
| Salinity [mol ⋅ dm-3 NaCl] ↷ |
|---|
| NaCl min.: 0.23 |
| NaCl max.: 0.69 |
| NaCl optimal min.: 0.46 |
| NaCl optimal max.: 0.46 |
| Growth rate ↷ |
|---|
| Growth rate: 0.063 |
| Doubling time [h]: 11 |
| Morphology ↷ |
|---|
| Motility: no |
| Shape: Irregular cocci |
| Gram reaction: negative |
| Cell surface structures (flagella, pili, fimbriae): present |
| Cell dimensions [μm] ↷ |
|---|
| Width min.: 2.6 |
| Width max.: 2.6 |
| Length min.: 2.6 |
| Length max.: 2.6 |
| Sources ↷ |
|---|
| Main: J. Romesser et al., 1979, Arch. Microbiol., vol. 121, p. 147 |
| Other: H. Zabel et al., 1984, Arch. Microbiol., vol. 37, p. 308 |
| Environment ↷ |
|---|
| Water sediments |
| Description: Sediment collected at station 2030 on R. V. Atlantis II cruise 79 in the Cariaco Trench. |
| Strain info ↷ |
|---|
| Type strain: JR1 |
| DSM: DSM-1497 |
| ATTC: ATCC 35093 |
| Other collections: JCM 10550, OCM 49, OCM 155 |
| G+C content: 52 |
| Substrate ↷ |
|---|
| H2+CO2: Yes |
| Formate: Yes |
| Acetate: No |
| Methanol: No |
| Methylamin: no data |
| Di-methylamin: no data |
| Tri-methylamin: no data |
| CO: No data |
| Ethanol: no data |
| 1-propanol: no data |
| 1-butanol: No data |
| 2-butanol: No data |
| 2-propanol: No data |
| Butanol: No data |
| Cyclopentanol: no data |
| Isobutanol: No data |
| Dimethyl sulfide: no data |
| H2+Methanol: No data |
| Other: no data |
| Download sequences |
|---|
| All nucleotide sequences |
| Protein genes - nucleotide sequences |
| rRNA sequences |
| tRNA sequences |
| Protein genes - aminoacid sequences |